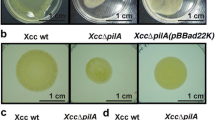

Abstract
Type IV pili of X. fastidiosa are regulated by pilG, a response regulator protein putatively involved in chemotaxis-like operon sensing stimuli through signal transduction pathways. To elucidate the roles of pilG in pathogenicity of X. fastidiosa, the pilG-deletion mutant XfΔpilG and complemented strain XfΔpilG-C were generated. While all strains had similar growth curves in vitro, XfΔpliG showed significant reduction in cell-matrix adherence and biofilm production compared with wild-type X. fastidiosa and XfΔpilG-C. The genes pilE, pilU, pilT, and pilS were down-regulated in XfΔpliG when compared with its complemented strain and wild-type X. fastidiosa. Finally, no Pierce’s disease symptoms were observed in grapevines inoculated with XfΔpilG, whereas grapevines inoculated with the wild-type X. fastidiosa and complemented strain of XfΔpilG-C developed typical Pierce’s Disease (PD) symptoms. The results indicate that pilG has a role in X. fastidiosa virulence in grapevines.
Similar content being viewed by others
Avoid common mistakes on your manuscript.
Introduction
Xylella fastidiosa is an important pathogenic bacterium that causes a number of economically important diseases, including citrus variegated chlorosis (CVC) in South America (Chang et al. 1993; Hartung et al. 1994) and Pierce’s disease of grapevines (PD) in North America (Purcell and Hopkins 1996; Purcell 1997). X. fastidiosa is a Gram-negative non-flagellated bacterium and limited to the water-conducting xylem vessels. PD results in the blockage of xylem vessels, water stress and nutritional deficiencies (Hopkins 1989). The twitching motility of X. fastidiosa, a means of flagellum-independent bacterial movement through extension, attachment and retraction of the polar type IV pili (Mattick 2002), has been microscopically characterized in a fabricated microfluidic chambers (Li et al. 2007; Meng et al. 2005). The colonization of xylem vessels is dependent on the ability of X. fastidiosa to move within xylem vessels (Meng et al. 2005). The pilB, pilQ, and pilR mutants resulting in the defect of type IV pili and non-twitching phenotypes showed reduced disease symptoms in grapevines (Li et al. 2007; Meng et al. 2005). These suggest that twitching motility provides X. fastidiosa not only a means for long-distance intra-plant movement and colonization but also contributes toward virulence.
X. fastidiosa type IV pili possess major structural protein (PilA) and minor proteins involved in formation of the base and/or tip of the pilus (PilE, PilV, and FimT). In addition, proteins, PilB, PilC, PilQ, PilT and PilU are required for pilus assembly and retraction (Mattick 2002; Simpson et al. 2000). The transcription of pilA was regulated by pilR, a response regulator in a two-component sensor-regulator pair pilS/pilR system (Winther-Larsen and Koomey 2002). The activity of twitching motility of X. fastidiosa was controlled by a chemotaxis-like regulatory system (Cursino et al. 2011), Pil-Chp operon, similar to that in P. aeruginosa and E. coli (Ferandez et al. 2002; Fulcher et al. 2010; Hazelbauer et al. 2008; Kirby 2009). Like P. aeruginosa CheIV (Pil-Chp) cluster (Ferandez et al. 2002; Fulcher et al. 2010), X. fastidiosa possesses a single predicated chemosensory system, Pil-Chp operon that regulates the twitching motility of type IV pili (Fulcher et al. 2010; Simpson et al. 2000). Pil-Chp operon of X. fastidiosa encodes proteins involved in signal transduction pathways including pilG, pilI, pilJ, pilL, chpB and chpC as in P. aeruginosa and E. coli (Cursino et al. 2011; Fulcher et al. 2010; Kirby 2009). Upon binding of the chemical stimuli in the periplasmic domain, the transmembrane chemoreceptors activate a signaling cascade in the cytoplasmic portion and ultimately control bacterial twitching motility (Cursino et al. 2011). A phospho-shuttle protein PilG in Pil-Chp operon of X. fastidiosa is homologous to CheY, a response regulator in chemotaxis systems of E. coli and P. aeruginosa, in which CheY interacts with the flagellar motor proteins (Ferandez et al. 2002; Fulcher et al. 2010). Recent studies indicated that the homologue of chemotaxis regulator, PilG is required for the twitching motility of X. fastidiosa since the deleted pilG X. fastidiosa strain was deficient in twitching motility (Shi and Lin 2016).
The critical roles of the Pil-Chp operon in the virulence in X. fastidiosa were examined recently (Cursino et al. 2011). However, the contributions of pilG in Pil-Chp chemotaxis operon toward the pathogenicity of X. fastidiosa are not clear. In this study, the functional roles of chemotaxis regulator PilG involving in biofilm, cell adherence and pathogenicity are discussed.
Materials and methods
Bacterial strains
Bacterial strains of E. coli and X. fastidiosa Temecula (Costa et al. 2004) used in this work are listed in Table 1. X. fastidiosa Temecula strain and derivatives were cultured at 28 °C on solid PD2 medium (Davis et al. 1981). When required, PD2 medium was supplemented with 10 μg/ml gentamicin (Gm) and 10 μg/ml chloramphenicol (Cm).
Sequence analysis and domain identifications
Complete genome sequences of P. aeruginosa PAO1(AE004091.2), Xanthomonas citris (GCA_001498875.1) and X. fastidiosa Temecula (NC_004556.1) were obtained from NCBI GenBank. Type IV pilin-related gene homologous analysis was performed with blastn, blastp and tblastn, using X. fastidiosa Temecula genome sequence data as a query against the reference genomes. Functional domains were predicted and identified through Conserved Domain Database PROSITE (Sigrist et al. 2005).
Construction of XfΔpilG mutant and XfΔpilG-C complemented strain
An XfΔpilG mutant of X. fastidiosa was generated by deleting pilG ORF using a double-crossover homologous recombination strategy as described previously (Shi et al. 2007). In brief, two PCRs were performed to generate DNA fragments to the left side (primers pilGA and pilGB) and the right side (primers pliGC and pilGD) of the pilG ORF (PD0845) (Table 1). This two PCR strategy ensures that the entire ORF of pilG is precisely replaced with Gm cassette without disrupting downstream operon genes. Five μl of the left and the right of amplified DNA fragments were then purified, mixed and denatured at 95 °C for 5 min. Double strands were annealed at overlapping barcode regions in primers pilGB and pilGC (indicated with italics in Table 1) at 25 °C for 10 min. The mixture was then amplified by PCR with a pair of primers pilGA and pilGD to generate a 1.159-kb fragment, which was then cloned into the pGEM-T Easy (Promega, WI) to make pUC0845 (Table 1). A Gm cassette from the pGEM-T-GM (Table 1) was excised and cloned into AscI site of a 1.159-kb PCR fragment in pUC0845, resulting in the mutant construct pUC08451 (Table 1). About two micrograms of pUC08451 DNA in a volume of 10 μl was electroporated into electrocompetent cells of X. fastidiosa Temecula under the conditions described previously (Shi et al. 2007). Electroporated cells were then incubated in PD2 broth on a shaker at 200 rpm for 24 h and followed by plating cells on PD2 agar medium supplemented with 10 μg/ml Gm. Gm-resistant clones that grew on selective media were identified as potential XfΔpilG mutant strains. The successful insertion of Gm cassette into X. fastidiosa genome was further confirmed by PCR using primers M13For/Rev., pilGChFor/Rev. and CmF/R, respectively (Table 1). The location and sequences of the Gm cassette in genomic DNA of X. fastidiosa was also confirmed through resequencing respective amplicons.
The complemented strain XfΔpilG-C was constructed through the chromosome-based genetic complementation strategy as described earlier (Matsumoto et al. 2009). In brief, a 0.693-kp of fastidiosa Temecula genomic DNA containing the pilG promoter and open reading frame (ORF) was amplified by PCR using the primers pilGXFExpFor and pilGXFExpRev (Table 1). The PCR-amplified fragment was cloned into AscI site of pUC129PDCm to make pUCpilG Xf-Exp (Table 1). The cloned PCR fragment (pilG promoter and ORF) in pUCpilG Xf-Exp was confirmed by resequencing amplicons. One microgram of the plasmid pUCpilG Xf-Exp DNA in a volume of 5 μl was then electroporated with 50 μl of XfΔpilG electrocompetent cells under the conditions described earlier (Shi et al. 2009). Electroporated XfΔpilG cells were plated on PD2 agar medium supplemented with 10 μg/ml Gm and 10 μg/ml Cm. Clones that survived on selected medium were identified as complemented XfΔpilG cells. The successful complemented strain XfΔpilG-C was confirmed by PCR using primers pUCFor/Rev and CmF/PD0730Rev (Table 1) and validated by resequencing of respective amplicons.
Gene expression assays
Total RNA was extracted from the cells of wild-type, XfΔpilG, and XfΔpilG-C grown in PD2 liquid media agitated at 200 rpm for 5 days at 28 °C (Chuang et al. 1993; Kustu et al. 1989). The extracted RNA samples were treated with DNA-free DNase (2 U/μl) to remove residual DNA contamination following the manufacturer’s instruction (Ambion, TX). RNA samples were then quantified by a spectrophotometer and adjusted to 0.5 μg/μl (Kustu et al. 1989). To confirm that deletion of pilG does not cause frameshift mutation on downstream genes (pilI, pilJ, pilL, chpB and chpC), reverse transcription polymerase chain reaction (RT-PCR) was carried out using OneStep RT-PCR (Invitrogen, CA) with corresponding primer pairs (Supplementary Table S1), under the conditions: 45 °C for 60 min and then 95 °C for 5 min, and followed by 30 cycles of 95 °C for 30 s, 55 °C for 40 s and 72 °C for 1 min, and ended at 72 °C for 10 min. PCR products were separated by 1% agarose gel.
To investigate the effect of pilG mutant on genes involved in the type IV twitching motility and virulence, fifteen genes were selected for gene expression assay (Table 2). One μg of total RNA from wild-type, XfΔpilG, and XfΔpilG-C was synthesized into single strand cDNA via reverse transcription according to manufacturer’s protocol (Invitrogen, CA). Quantitative PCR (qPCR) was then carried out using 0.5 μl of cDNA and 2 μl of 5 pmol/μl gene-specific forward and reverse primers (Table 2) in a 20 μl of real-time PCR mixture. PCR was conducted with the following conditions: 50 °C for 2 min, 95 °C for 10 min and followed by 40 cycles of 95 °C for 15 s, 60 °C for 30 s and 72 °C for 30 s and end at 72 °C for 10 min on a IQ5 PCR system using Universal SYBR green super-mix (Bio-Rad, CA). Results were analyzed using ΔΔC T calculation method (Giampetruzzi et al. 2016; Petriccione et al. 2015) where the ∆ΔC T is the difference in threshold cycle between the target gene and housekeeping gene: ∆∆C T = ∆C T (target gene) - ∆C T (housekeeping gene). The final result of the calculation is presented as the fold change of target gene expression (mutant or complemented stain) relative to a reference sample (wild-type), normalized to a reference gene (housekeeping gene). The relative gene expression is then set to 1 for reference samples as when ΔΔC T is equal to 0 (20 is equal to 1). There were three biological replicates and each sample was repeatedly measured three times.
Phenotypic analyses
To evaluate the effect of pilG-deficiency on cell growth, all X. fastidiosa strains were cultured in vitro in PD2 broth at 28 °C from day 3 to day 9. Cell concentration was determined by measuring turbidity at OD600nm (Shi et al. 2009). To analyze the cell attachment, each strain was cultured in a 5 ml Erlenmeyer tube containing 2 ml of PD2 broth. The tubes were maintained in an incubator for 10 days at 28 °C at 120 rpm rotation speed. The cell attachment on the walls of the tube was then assayed using crystal violet dye method (Burdman et al. 2000; Leite et al. 2004). The quantification of biofilm formation was assessed in 96-well microtiter culture plates as described previously (Leite et al. 2004; Shi et al. 2007). All strains were first cultured in PD2 broth at 28 °C without shaking for 4 days. Bacterial cells were then collected and adjusted to an OD600nm of 0.02. About 150 μl from each culture were transferred to a well in 96-well microtiter plates. Bacterium-free PD2 broth was used as negative control. Microtiter plates were incubated at 28 °C without shaking for 12 days. Each treatment had three replications, and experiments were repeated three times.
Pathogenicity assays
The cells of wild-type, XfΔpilG, and XfΔpilG-C grown on PD2 agar medium for 5 days at 28 °C, were suspended in phosphate buffered saline (PBS) and adjusted to an OD600nm of 0.10 (~ 6.15 × 107 cells/ml). A drop of 20 μl of cell suspension was used to inoculate grapevine, V. vinifera L. ‘Chardonnay’. A semi-lignified stem 10 cm above the base was pierced by a needle, allowing the droplet to be taken into the stem vascular system by transpiration flow. Each plant was inoculated twice to ensure successful inoculation and five plants were used for each treatment as previously described (Shi et al. 2009). A phosphate buffered saline (PBS) buffer served as a mock inoculation. Greenhouse temperatures were maintained between 20 °C and 32 °C. An average day/night cycle of 18/6 h was obtained through a combination of ambient and supplemental lighting. Plants were irrigated with 1.9 L/h emitters for 2 min per day (Fritschi et al. 2007). The PD symptoms were rated based on a visual scale from 0 to 5 with zero as healthy and 5 for the most severe as described previously (Guilhabert and Kirkpatrick 2005; Krivanek et al. 2005). The disease index was an average from five replications for each X. fastidiosa strain. Experiments were repeated three rounds under the same greenhouse conditions.
Bacterial titer measurement
Ten weeks after inoculation, multiple petiole tissues were harvested above the inoculation point from each vine inoculated with the wild-type, XfΔpilG, XfΔpilG-C strain, respectively, for DNA extraction. The successful inoculation was confirmed by PCR using Xf specific Rst31/33 primers (Minsavage et al. 1994). Bacterial titer measurement was performed at week 20 post inoculation. DNA was extracted again from all experimental plants (Lin et al. 2007). The titers of bacteria in the samples were estimated using qPCR according to the method described earlier (Francis et al. 2006). The means of bacterial titers were obtained from five replicates in each round of experiment.
Statistical analysis
All experiments with various treatments had 3–5 replications and were repeated at least three times. The statistical significance was calculated using ANOVA at 99% (p < 0.01) and 95% (p < 0.05).
Results
Sequence analysis
Sequence analysis of the Pil-Chp gene cluster revealed homology to the P. aeruginosa CheIV chemotaxis operon. Genes in Pil-Chp cluster of X. fastidiosa are organized in tandem with PilG in farthest upstream followed by pilI-pilJ-pilL and chpB-chpC parallel to the order of P. aeruginosa CheIV operon except for missing pilH and pilK. The pilL is predicted to contain several conserved domains of ChpA proteins. These results agree with the earlier report (Cursino et al. 2011; Wuichet et al. 2007). Conserved domain analysis indicates that pilG contains one phosphorylation site, five intermolecular recognition sites and three dimerization interface sites (Fig. 1). pilG is predicted to encode a response regulator homologue of CheY protein. This domain receives the signal from the sensor partner in a two-component system with a phosphor-acceptor site that is phosphorylated through histidine kinase homologs, commonly found at N-terminal to a DNA binding effector domain. Sequence analysis also hit OmpR, a DNA-binding response regulator (Fig. 1).
Organizations of the pilG-I-J-L and chpB-C gene cluster of X. fastidiosa Temecula strain and the Pseudomonas aeruginosa CheIV cluster operon. Arrows indicate the direction of transcription of the genes. An open triangle represents phosphorylation site. Solid triangles represent intermolecular recognition sites and solid rectangles represent dimerization interfaces
pilG deletion mutant and complemented strain preparation
pilG-knock-out strain XfΔpilG was successfully obtained from the colonies grown on agar PD2 medium supplemented with 10 μg/ml Gm antibiotics. The location of Gm cassette was confirmed by resequencing respective locus where the ORF of pilG was replaced with Gm cassette. The downstream genes (pili, pilJ, pilL chpB and chpC) in Pil-Chp operon were expressed (Supplementary Fig. S1). The chromosome-based complemented XfΔpilG was also obtained from the colonies that survived on the medium supplemented with 10 μg/ml Gm and 10 μg/ml Cm antibiotics. Due to technical limitations, complemented strain XfΔpilG was generated by inserting the pilG gene (promoter and ORF) along with Cm cassette at intergenic loci between two pseudogenes, PD0702 and PD0703. The insertion of pilG gene (promoter and ORF) in complemented strain was confirmed by resequencing respective locus. Stable XfΔpilG and XfΔpilG-C colonies were obtained after five to eight streaks on PD2 agar medium supplemented with said antibiotics. The expression of pilG was not detected in XfΔpilG but detected in complemented XfΔpilG-C (Supplementary Fig. S1).
Cell growth, attachment and biofilm formation
No significant difference in cell growth was observed between wild-type, XfΔpilG and XfΔpilG-C strains after nine days growth in liquid culture. The growth curves of the XfΔpilG mutant and complemented XfΔpilG-C strains paralleled wild-type, suggesting that deletion of pilG do not affect cell growth. All three strains showed similar growth curves (Fig. 2). X. fastidiosa and XfΔpilG-C strains attached to the inner surface of walls of the tubes and formed wide rings whereas no cell-attached ring was observed in XfΔpilG cells (Fig. 3a). The biofilm formation of XfΔpilG was about 5–6 folds less than that of wild-type and XfΔpilG-C strain (P < 0.01) (Fig. 3b).
Cell attachment and biofilm formation analysis of wild-type X. fastidiosa, XfΔpilG and XfΔpilG-C strains in PD2 broth. a Cells attached to the inside wall of the glass tubes forming a ring. b Quantitative measurement of biofilm formation of wild-type, XfΔpilG and XfΔpilG-C trains. Data are the average of three replications with error bars indicating standard deviation. Bars with the different lowercase letter are significantly different from each other (P < 0.01), no significant difference was indicated as the same letter. The experiments were repeated three times
Gene expressions associated with Pil-Chp pili system
No significantly differential expression was detected in virulence transcriptional regulator csrA and gcvR, and two-component system regulator gacA in XfΔpilG and XfΔpilG-C strains compared to wild-type strain (Fig. 4). However, the expression of the Type IV pilin pilE, twitching mobility genes pilU and pilT, and the Type IV fimbriae expression two-component system regulator pilS were 2-fold or more down-regulated in strain XfΔpilG compared with wild-type and XfΔpilG-C strains (P < 0.05) (Fig. 4). The housekeeping gene dnaQ (DNA polymerase III) was expressed constantly in all strains (data not shown).
Differential expressions of several pil and regulatory genes involved in the Type IV pili. Expression levels were compared between strain XfΔpilG vs wild-type or strain XfΔpilG-C vs wild-type. Housekeeping gene dnaQ (DNA polymerase III) was used as control. Gene expressions in wild-type were normalized to one. The positive and negative along Y-axis indicate up or down regulation in relation to the wild-type. Data are plotted as fold-change measured by real-time PCR. Each sample was repeated three times
Pathogenicity assay
The grapevines inoculated with wild-type X. fastidiosa and strain XfΔpilG-C developed typical Pierce’s disease symptoms while plants inoculated with strain XfΔpilG showed no symptoms 12 weeks post inoculation. No PD symptoms were observed in PBS-inoculated control grapevines (Fig. 5). All inoculated grapevines were X. fastidiosa-positive and no X. fastidiosa was detected in PBS inoculated grapevines.
Pathogenicity assays on Chardonnay grapevines inoculated with PBS (negative control), wild-type X. fastidiosa, XfΔpilG and XfΔpilG-C strains 20 weeks post-inoculation in the greenhouse. Grapevines from each treatment group developed Pierces disease symptoms ranging from healthy to severe. Greenhouse experiments were repeated three times in 2013, 2014 and 2015
Bacterial titers
The titers of bacterium inoculated with wild-type, XfΔpilG and XfΔpilG-C strains were determined using quantitative PCR. The titers of XfΔpilG strain were about only 20% of wild-type (P < 0.001) while the titers of complemented XfΔpilG-C were about 63% of wild-type (P < 0.05), significantly higher than mutant strain XfΔpilG but lower than that of wild-type (Fig. 6). The data were averaged from five replicates. The experiments were independently repeated three times.
Populations of wild-type X. fastidiosa, XfΔpilG and XfΔpilG-C strains from Chardonnay grapevine petioles were estimated by q-PCR twenty weeks post-inoculation. Data were means from five replications. Different letters indicate ANOVA-test results of significance (P < 0.05). Experiments were repeated three times from 2013 to 2015
Discussion
Twitching motility is a flagellum-independent form of bacterial translocation over moist surfaces mediated by type IV pili (Burrows 2012; Mattick 2002). Previously, we have shown that pilG plays a key functional role in type IV pilus-dependent twitching motility (Shi and Lin 2016). The results presented in this study show that twitching motility in X. fastidiosa is modulated by a two-component regulatory system that possesses a sequence homologous to bacterial chemotaxis system (Bertrand et al. 2010). In contrast to other gram-negative bacteria, such as P. aeruginosa and E. coli, which contain either multiple chemotaxis operons or multiple chemoreceptors (Ferandez et al. 2002; Fulcher et al. 2010; Hazelbauer et al. 2008; Kirby 2009), only a single chemotaxis operon and chemoreceptor in Pil-Chp operon were identified in X. fastidiosa (Cursino et al. 2011; Simpson et al. 2000). Such a unique feature likely reflects its lifestyle that X. fastidiosa has specifically adapted to the inside of host xylem vessels where physical and chemical complexities are much less compared to free living bacteria (Cursino et al. 2011). Sequence analysis revealed that the transcriptional orientation of chemotaxis genes is organized into a gene cluster with pilG located in the first upstream position (Fig. 1). There are six genes in this operon in an order pilG, pilI, pilJ, pilL and chpB terminating at chpC (Fig. 1). Together with the pilG-I-J-L and ChpB-C, the Pil-Chp constitutes a signal transduction system analogous to P. aeruginosa chemotaxis system that mediates rotation of pili in response to chemical attractants or repellents. In X. fastidiosa, pilG in Pil-Chp operon is predicted to encode a phospho-shuttle protein (Simpson et al. 2000) which is homologous to a response regulator CheY in P. aeruginosa Pil-Chp operon (Ferandez et al. 2002; Fulcher et al. 2010). By using the microfluidic chamber devices, our previous studies provide visual evidence that the X. fastidiosa pilG mutant strain is deficient in motility in vitro while the complemented strain fully restored twitching motility indicating that pilG is indispensable to Type IV pilus twitching motility in X. fastidiosa (Shi and Lin 2016). In host, flagellum-independent X. fastidiosa is capable of actively moving against the xylem stream, colonizing grape xylem vessels and subsequently developing PD. Apparently, the twitching motility of the type IV pilus and colonization through biofilm formation and cell-cell aggregation facilitate the intra-plant spread (Meng et al. 2005; Newman et al. 2003; Stevenson et al. 2004). This phenomenon was also observed in other bacterial pathogens, such as Ralstonia solanacearum and P. aeruginosa which possess a similar twitching-mediated migration mechanism (Darzins 1993, 1994; Liu et al. 2001; Whitchurch et al. 2004). Though the molecular mechanisms of pilG regulating the pilus biosynthesis and regulatory response network in X. fastidiosa is yet to be revealed, sequence analysis reveals that genes in Pil-Chp operon of X. fastidiosa are close in proximity to each other and transcribed with the transcriptional orientation from pilG to the transcriptional terminating of chpC (Cursino et al. 2011). The biosynthesis, assembly, and function of type IV pili require more than 20 genes (Mattick 2002). Regulation of Type IV pili function involves several signal transduction systems including two-component signaling systems (Bertrand et al. 2010). For example, pilE encodes the minor proteins involved in formation of the base and/or tip of the pilus. The expression of pilE was down-regulated in pilG deleted strain compared to its wild-type and strain XfΔpilG-C suggesting that pilG has a functional role in regulation of the pilus production. In X. fastidiosa, the pilT and pilU genes are contiguous on the chromosome but reside in a locus separated from other genes involved in pilus biosynthesis and related functions. The gene expressions of pilU and pilT which encode the proteins required for pilus assembly and retraction (Mattick 2002; Simpson et al. 2000) were also down-regulated in strain XfΔpilG while the levels of pilU and pilT gene expression were restored in the pilG complemented strain. Our data further indicated that pilS, two component sensor–regulator involved in the regulation of the transcription of pilA was also down regulated in pilG mutant. The expression of pilS was restored close to wild-type levels in complemented strains. As for CheY in P. aeruginosa (Darzins 1993, 1994; Whitchurch et al. 2004), pilG is a regulator in the chemosensory system in Pil-Chp operon, therefore it seems that pilG plays a central role in the coordination of pilus biosynthesis, assembly and retraction in response to the environmental stimuli signals.
In this study, we demonstrate that pilG is also associated with several virulence properties including cell attachment, biofilm formation and PD development in grapevines. While virulence genes are critical for determinants of pathogenicity they are not essential for bacterial survival (Rasko and Sperandio 2010). Thus, pilG mutant strain showed similar growth curve as wild-type when both grow in rich medium (Fig. 2). Results from in vitro studies indicated that deletion of pilG caused significant reduction in cell attachment and biofilm formation whereas the pilG complemented strain restored wild-type phenotypes (Fig. 3). In planta pathogenicity assessment further confirmed that grapevine inoculated with pilG complemented strains developed typical PD symptoms with severity comparable to the wild-type. In contrast, grapevines inoculated with pilG mutant strains exhibited no visible symptoms in three independent greenhouse experiments (Fig. 5). The titers of three strains of X. fastidiosa well correlated the severity of disease symptoms (Fig. 6). Defect of motility does not necessarily result in loss of virulence. Several X. fastidiosa twitching motility-associated mutants have been reported (Li et al. 2007; Meng et al. 2005). Most of these were found in partial reduction in virulence and PD symptoms (Cursino et al. 2009; Meng et al. 2005). More recently, Cursino et al. (2009) reported that tonB1 mutant showed only 30% of reduction in virulence as compared with its wild-type X. fastidiosa although tonB1 mutant caused motility deficiency. These results could be largely due to the fact that motility deficiency X. fastidiosa could be passively spread through the xylem evapotranspiration stream. In this study, however, we found that the pathogenicity was completely knocked-out in pilG mutant. To this regard, combining our in vitro and in vivo data we conclude that pilG may have several roles involving multiple regulatory functions and pathogenicity, therefore is a central protein in mediating PD development. In this study, we used a chromosome-based complementation method. Genome-based transformation provides stable and single copy in contrast to the plasmid complementation approach which usually yields high-copy and is unstable. The complemented pilG successfully restored wild-type phenotype as confirmed by in vitro and in planta experiments. However, it should be noted that gene expression of complemented strain of pilG was not quite to the levels of wild-type, presumably due to the fact that complementation was accomplished at the locus rather than native location in X. fastidiosa genome. The position effect on gene expression has been reported in E. coli (Bryant et al. 2014).
While the exact molecular mechanisms by which PilG regulates the twitching motility and pathogenicity in X. fastidiosa require further investigation, results from this study demonstrate that PilG is a critical component of the regulatory hierarchy governing the pathogenicity of X. fastidiosa in response to environmental signals. Those results will provide a new target to develop gene-based therapeutics for disrupting the pathogenicity of X. fastidiosa to control Pierce’s disease.
References
Bertrand, J. J., West, J. T., & Engel, J. N. (2010). Genetic analysis of the regulation of type IV pilus function by the Chp chemosensory system of Pseudomonas aeruginosa. Journal of Bacteriology, 192(4), 994–1010.
Bryant, J. A., Sellars, E., Busby, J. W., & Lee, D. J. (2014). Chromosome position effects on gene expression in Escherichia coli K-12. Nucleic Acids Research, 42(18), 11383–11392.
Burdman, S., Jurkevitch, E., Soria-Diaz, M. E., Serrano, A. M. G., & Okon, Y. (2000). Extracellular polysaccharide composition of Azospirillum brasilense and its relation with cell aggregation. FEMS Microbiology Letters, 189(2), 259–264.
Burrows, L. L. (2012). Pseudomonas aeruginosa twitching motility: type IV pili in action. Annual Review of Microbiology, 66, 493–520.
Chang, C. J., Garnier, M., Zreik, L., Rossetti, V., & Bove, J. M. (1993). Culture and serological detection of the xylem-limited bacterium causing citrus variegated chlorosis and its identification as a strain of Xylella fastidiosa. Current Microbiology, 27(3), 137–142.
Chuang, S. E., Daniels, D. L., & Blattner, F. R. (1993). Global regulation of gene expression in Escherichia coli. Journal of Bacteriology, 175(7), 2026–2036.
Costa, H. S., Raetz, E., Pinckard, T. R., Gispert, C., Hernandez-Martinez, R., Dumenyo, C. K., & Cooksey, D. A. (2004). Plant hosts of Xylella fastidiosa in and near southern California vineyards. Plant Disease, 88(11), 1255–1261.
Cursino, L., Li, Y., Zaini, P. A., De La Fuente, L., Hoch, H. C., & Burr, T. J. (2009). Twitching motility and biofilm formation are associated with tonB1 in Xylella fastidiosa. FEMS Microbiology Letters, 299(2), 193–199.
Cursino, L., Cheryl, D., Galvani, D. A., Zaini, P. A., Li, Y., De La Fuente, L., Hoch, H. C., Burr, T. J., & Mowery, P. (2011). Identification of an operon, Pil-Chp,that controls twitching motility and virulence in Xylella fastidiosa. Molecular Plant-Microbe Interactions, 24(10), 1198–1206.
Darzins, A. (1993). The pilG gene product, required for Pseudomonas aeruginosa pilus production and twitching motility, is homologous to the enteric, single-domain response regulator CheY. Journal of Bacteriology, 175(18), 5934–5944.
Darzins, A. (1994). Characterization of a Pseudomonas aeruginosa gene cluster involved in pilus biosynthesis and twitching motility: Sequence similarity to the chemotaxis proteins of enterics and the gliding bacterium Myxococccus xanthus. Molecular Microbiology, 11(1), 137–153.
Davis, M. J., French, W. J., & Schaad, N. W. (1981). Axenic culture of the bacteria associated with phony peach disease of peach and plum leaf scald. Current Microbiology, 6(5), 309–314.
Ferandez, A., Hawkins, A. C., Summerfield, D. T., & Harwood, C. S. (2002). Cluster II che genes from Pseudomonas aeruginosa are required for an optimal chemotactic response. Journal of Bacteriology, 184(16), 4374–4383.
Francis, M., Lin, H., Rosa, J., Doddapaneni, H., & Civerolo, E. L. (2006). Genome-based PCR primers for specific and sensitive detection and quantification of Xylella fastidiosa. European Journal of Plant Pathology, 115, 203–213.
Fritschi, F. B., Lin, H., & Walker, M. A. (2007). Xylella fastidiosa population dynamics in grapevine genotypes differing in susceptibility to Pierce’s disease. American Journal of Enology and Viticulture, 58(3), 326–332.
Fulcher, N. B., Holliday, P. M., Klem, E., Cann, M. J., & Wolfgang, M. C. (2010). The Pseudomonas aeruginosa Chp chemosensory system regulates intracellular cAMP levels by modulatine adenylate cyclase activity. Molecular Microbiology, 76(4), 889–904.
Giampetruzzi, A., Morelli, M., Saponari, M., Loconsole, G., Chiumenti, M., Boscia, D., Savino, V. N., Martelli, G. P., & Saldarelli, P. (2016). Transcriptome profiling of two olive cultivars in response to infection by the CoDiRO strain of Xylella fastidiosa subsp. Pauca. BMC Genomics, 17, 475.
Guilhabert, M. R., & Kirkpatrick, B. C. (2005). Identification of Xylella fastidiosa antivirulence genes: hemagglutinin adhesins contribute to Xylella fastidiosa biofilm maturation and colonization and attenuate virulence. Molecular Plant-Microbe Interactions, 18(18), 856–868.
Hartung, J. S., Beretta, J., Brlansky, R. H., Spisso, J., & Lee, R. F. (1994). Citrus variegated chlorosis bacterium: axenic culture, pathogenicity, and serological relationships with other strains of Xylella fastidiosa. Phytopathology, 84(6), 591–597.
Hazelbauer, G. L., Falke, J. J., & Parkinson, J. S. (2008). Bacterial chemoreceptors: High-performance signaling in networked arrays. Trends in Biochemical Sciences, 33(1), 9–19.
Hopkins, D. L. (1989). Xylella Fastidiosa: Xylem-limited bacterial pathogen of plants. Annual Review of Phytopathology, 27, 271–290.
Kirby, J. R. (2009). Chemotaxis-like regulatory systems: unique roles in diverse bacteria. Annual Review of Microbiology, 63, 45–59.
Kovach, M. E., Elzer, P. H., Hill, D. S., Robertson, G. T., Farris, M. A., Roop II, R. M., & Peterson, K. M. (1995). Four new derivatives of the broad-host-range cloning vector pBBR1MCS, carrying different antibiotic-resistance cassettes. Gene, 166, 175–176.
Krivanek, A. F., Stevenson, J. F., & Walker, M. A. (2005). Development and comparison of symptom indices for quantifying grapevine resistance to Pierce’s disease. Phytopathology, 95(1), 36–43.
Kustu, S., Santero, E., Keener, J., Popham, D., & Weiss, D. (1989). Expression of σ54 (ntrA)-dependent genes is probably united by a common mechanism. Microbiological Reviews, 53(3), 367–376.
Leite, B., Andersen, P. C., & Ishida, M. L. (2004). Colony aggregation and biofilm formation in xylem chemistry-based media for Xylella fastidiosa. FEMS Microbiology Letters, 230(2), 283–290.
Li, Y., Hao, G., Galvani, C. D., Meng, Y., De La Fuente, L., Hoch, H. C., & Burr, T. J. (2007). Type I and type IV pili of Xylella fastidiosa affect twitching motility, biofilm formation and cell-cell aggregation. Microbiology, 153(3), 719–726.
Lin, H., Doddapaneni, H., Takahashi, Y., & Walker, M. A. (2007). Comparative analysis of ESTs involved in grape responses to Xylella fastidiosa infection. BMC Plant Biology, 7, 8.
Liu, H. L., Kang, Y., Genin, S., Schell, M. A., & Denny, T. P. (2001). Twitching motility of Ralstonia solanacearum requires a type IV pilus system. Microbiology, 147(12), 3215–3229.
Matsumoto, A., Young, G. M., & Igo, M. M. (2009). Chromosome-based genetic complementation system for Xylella fastidiosa. Applied and Environmental Microbiology, 75, 1679–1687.
Mattick, J. S. (2002). Type IV pili and twitching motility. Annual Review of Microbiology, 56, 289–314.
Meng, Y., Li, Y., Galvani, C. D., Hao, G., Turner, J. N., Burr, T. J., & Hoch, H. C. (2005). Upstream migration of Xylella fastidiosa via pilus-driven twitching motility. Journal of Bacteriology, 187(16), 5560–5567.
Minsavage, G. V., Thompson, C. M., Hopkins, D. L., Leite, C., & Stall, R. E. (1994). Development of a polymerase chain reaction protocol for detection of Xylella fastidiosa in plant tissue. Phytopathology, 84(5), 456–461.
Newman, K. L., Almeida, R. P. P., Purcell, A. H., & Lindow, S. E. (2003). Use of a green fluorescent strain for analysis of Xylella fastidiosa colonization of Vitis vinifera. Applied and Environmental Microbiology, 69(12), 7319–7327.
Petriccione, M., Mastrobuoni, F., Zampella, L., & Scortichini, M. (2015). Reference gene selection for normalization of RT-qPCR gene expression data from Actinidi deliciosa leaves infected with Pseudomonas syringae pv. actinidiae. Scientific Reports, 5(1696), 1–12.
Purcell, A. H. (1997). Xylella fastidiosa, a regional problem or global threat? Journal of Plant Pathology, 79(2), 99–105.
Purcell, A. H., & Hopkins, D. L. (1996). Fastidious xylem-limited bacterial plant pathogens. Annual Review of Phytopathology, 34, 131–151.
Rasko, D., & Sperandio, V. (2010). Anti-virulence strategies to combat bacteria-mediated disease. Nature Reviews, 9(2), 117–128.
Shi, X. Y., & Lin, H. (2016). Visualization of twitching motility and characterization of the role of the PilG in Xylella fastidiosa. Journal of Visualized Experiments, 8(110), e53816. doi:10.3791/53816.
Shi, X. Y., Dumenyo, C. K., Hernandez-Martinez, R., Azad, H., & Cooksey, D. A. (2007). Characterization of regulatory pathways in Xylella fastidiosa: genes and phenotypes controlled by algU. Applied and Environmental Microbiology, 73(21), 6748–6756.
Shi, X. Y., Dumenyo, C. K., Hernandez-Martinez, R., Azad, H., & Cooksey, D. A. (2009). Characterization of regulatory pathways in Xylella fastidiosa: genes and phenotypes controlled by gacA. Applied and Environmental Microbiology, 75(8), 2275–2283.
Sigrist, C. J. A., De Castro, E., Langendijk-Genevaux, P. S., Le Saux, V., Bairoch, A., & Hulo, N. (2005). ProRule: A new database containing functional and structural information on PROSITE profiles. Bioinformatics, 21(21), 4060–4066.
Simpson, A. J. G., Reinach, F. C., Arruda, P., et al. (2000). The genome sequence of the plant pathogen Xylella fastidiosa. Nature, 406(4792), 151–157.
Stevenson, J. F., Matthews, M. A., Greve, L. C., Labavitch, J. M., & Rost, T. L. (2004). Grapevine susceptibility to Pierce’s disease II: the progression of anatomical symptoms. American Journal of Enology and Viticulture, 55(3), 238–245.
Whitchurch, C. B., Leech, A. J., Young, M. D., Kennedy, D., Sargent, J. L., Bertrand, J. J., Semmler, A. B., Mellick, A. S., Martin, P. R., Alm, R. A., Hobbs, M., Beatson, S. A., Huang, B., Nguyen, L., Commolli, J. C., Engel, J. N., Darzins, A., & Mattick, J. S. (2004). Characterization of a complex chemosensory signal transduction system which controls twitching motility in Pseudomonas aeruginosa. Molecular Microbiology, 52(3), 873–893.
Winther-Larsen, H. C., & Koomey, M. (2002). Transcriptional, chemosensory and cell-contact-dependent regulation of type IV pilus expression. Current Opinion in Microbiology, 5(2), 173.
Wuichet, K., Alexander, R. P., & Zhulin, I. B. (2007). Comparative genomic and protein sequence analyses of a complex system controlling bacterial chemotaxis. Methods in Enzymology, 422, 1–31.
Acknowledgements
Funding for the project was supported by the United States Department of Agriculture, Agricultural Research Service. Trade names or commercial products in this publication are mentioned solely for the purpose of providing specific information and does not imply recommendation or endorsement by the United States Department of Agriculture. USDA is equal opportunity provider.
Author information
Authors and Affiliations
Corresponding author
Ethics declarations
We state there is no potential conflict of interest in regard to this study. This research does not contain any studies with human or animal subjects. The data represented in this article are original and have not been published in the public. Both authors have written, read and consented to the manuscript.
Rights and permissions
Open Access This article is distributed under the terms of the Creative Commons Attribution 4.0 International License (http://creativecommons.org/licenses/by/4.0/), which permits unrestricted use, distribution, and reproduction in any medium, provided you give appropriate credit to the original author(s) and the source, provide a link to the Creative Commons license, and indicate if changes were made.
About this article
Cite this article
Shi, X., Lin, H. The chemotaxis regulator pilG of Xylella fastidiosa is required for virulence in Vitis vinifera grapevines. Eur J Plant Pathol 150, 351–362 (2018). https://doi.org/10.1007/s10658-017-1282-x
Accepted:
Published:
Issue Date:
DOI: https://doi.org/10.1007/s10658-017-1282-x